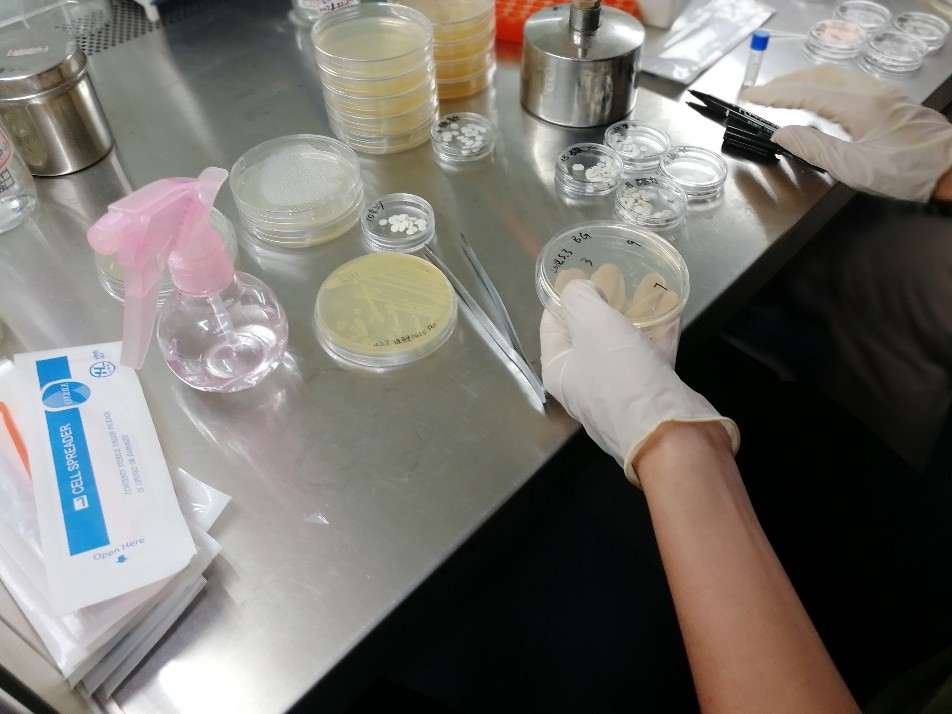
11.jpg

双螺旋基因第十期水产病害检测技术培训会成功举办
发布日期:2018年08月13日 阅读量:5月3日至4日,双螺旋基因联合广东省水生动物疫病预防中心举办第十期水产病害检测技术培训班。培训班为期1.5天,特别邀请中国水产科学研究院南海水产研究所徐力文副研究员、广东省水生动物疫病预防中心唐姝实验员作培训指导老师。双螺旋基因营销团队、技术支持团队、以及来自百博生物、大丰收生物、合泰渔业、恒海水产、誉丰水产等公司技术人员共20学员参加了本期培训。
广东省水生动物疫病预防控制中心颜远义副主任作开班讲话,颜副主任表示水产病害的防治任重而道远,贵在坚持与承担相应的责任,并祝愿学员们在未来两天认真学习,收获丰厚!

颜远义副主任讲话
第一天上午8:30,培训正式开始啦!

拥有丰富海水鱼病害检疫经验的徐力文老师,系统讲解了珠三角主要养殖鱼类与病害,内容包括不同地域鱼类的养殖分布、养殖模式的异同、引发病害的病原、流行趋势、诊疗方案等;此外,徐老师重点讲解了鱼类病害临床检测方法与技术,分享了自身三十多年一线的诊断经验,从病害的种类、症状初诊、镜检、细菌分离培养、分子方法确诊一一细述。
理论知识的是基础,病害的诊断离不开实验操作,下午实验培训包括鱼类解剖、病原镜检观察、细菌革兰氏染色、药敏实验。
解剖取样实验

徐老师指导学员们辨识鱼的各器官组织
学员两两分组练习解剖



显微镜检查实验

徐力文老师讲解常见的致病原,通过显微镜观察,辨认常见的寄生虫及细菌种类;
革兰氏染色实验
利用阴性菌和阳性菌细胞壁的厚度差异,通过不同染色剂染色、脱色,从细菌的所染的颜色区分阴性菌和阳性菌,阴性菌呈红色,阳性菌呈蓝色。



通过显微镜检查,细菌呈红色,可知细菌为革兰氏阴性菌。
药敏实验

学员们分别选择4~5种不同的抗生素浸泡纸片,在培养基上涂布细菌后,把纸片贴在培养皿的不同位置,写上日期编号,置于恒温培养箱中培养12小时。通过抑菌圈的大小,初步筛选出效果明显的药物。

经12小时培养后,可观察到不同药物的抑菌圈大小。
恒温PCR技术培训
第二天上午,由双螺旋基因技术支持工程师王海青为学员们培训恒温PCR技术应用于水产病害检测的理论知识与实验操作。
技术与产品介绍
实验操作培训包括取样、样品处理、样品核酸提取、加样、上机、结果查看等。
培训结束,经考核合格后,学员们获得了由广东省水生动物疫病预防中心颁发的技能培训结业证书。





